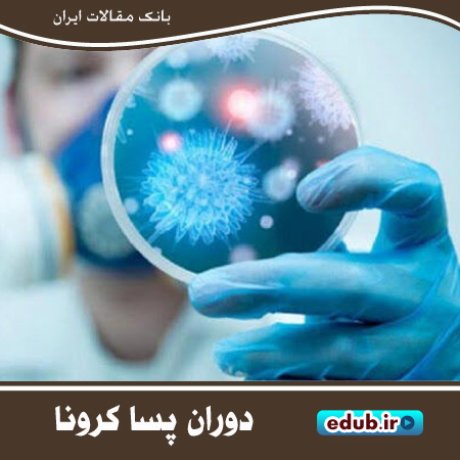

زنگ بازگشایی مدارس و تحقق عدالت آموزشی
آغاز سال تحصیلی و ضرورت برنامهریزیهای لازم
مهدی بلالی مود؛ پدر علم سمشناسی ایران
مروری بر کتاب کارآفرینی ، مراکز رشد و پارکهای علم و فناوری
حکایت تلخی و شیرینی سال جدید تحصیلی
کتاب «بهای دیدار» گزارهای از سبک زندگی طرح آیههای فراموش شده
تظاهرات عید فطر ۵۷؛ ضربهای بر پیکر نیمه جان رژیم پهلوی
ابوریحان بیرونی و آنچه از عاشورا نوشته است
قتل افشار طوس؛ دستاویزی برای فشار به دولت مصدق
حسین طاهرزاده و جریان سازی در موسیقی سنتی و کلاسیک معاصر
نیازهای روانی برای بازگشایی مراکز آموزشی
کاهش شکاف اقتصادی و اجتماعی با توسعه تعاونیها

مسعود مهرابی؛ خالق تاریخ سینمای ایران
آرتور ایهام پوپ؛ مردی که عاشق فرهنگ و معماری ایران بود
کتاب" بافت قدیم نصف جهان " کتابی درباره سه محله قدیمی اصفهان
محمود کاوه؛ سردار جوانی که رشادتهایش لرزه بر دشمن میانداخت
کتاب «آینه در آینه» مجموعهای از اشعار آیینی مدایح و مراثی
نگاهی به تاریخ خلیج فارس در کتاب «جزیره عشق»

پنج مجموعه شعر کردی از شاعران کرمانشاهی منتشر شد
کتاب «مُلازم اول؛ غواص»؛ کربلای چهار به روایت یک آزاده
بازخوانی واقعه عاشورا؛ راهبرد امام سجاد(ع) برای احیای شریعت اسلامی
کتاب «دوست من علوم» کتابی با سرودههای آموزشی
کتاب "زندهباد زایندهرود" کتابی با رویکرد زیست محیطی
جزئیات ترمیم حقوق کارمندان و بازنشستگان
کتاب «نگاههای بینگاه» کتابی با تصویری متفاوت از شهر اراک
مروری بر کتاب مواضع ما در ولایت و رهبری
چنگیز شهوق، مجسمهساز نوگرای معاصر
فرهاد مهراد؛ از عدالتخواهی در دوران ستمشاهی تا ترانههای مذهبی
کتاب «۴۴ راز عالی در فوتبال »کتابی مهیج و آموزنده
غلامرضا روحانی؛ طنزپرداز جریان ساز و «شاعر مشکلات مردم»
قیام عاشورا؛ جاودانهترین نام در تاریخ اسلام
کتاب نامیرا؛ بازآفرینی روایت کوفیان و تراژدی عاشورا
ایران یکی از قربانیان بزرگ تروریسم در جهان

کتاب «تبسم گل» فرهنگنامه شهدای شهرستان شازند
محمد باقر حکیم؛ عالمی سیاستمدار و پیشگام مبارزه با رژیم بعث
پژوهشی در اعقاب و بازماندگان حضرت عباس بن علی (علیه السلام)
الگوها و اسوه هاقمر بنی هاشم، عباس بن علی (ع)
نقش آفرینی حضرت عباس(علیه السلام) در حماسه عاشورا
حضرت عباس پرچم دار امام حسین علیه السلام
مصیبت ام البنین(س) مادر حضرت عباس(س)
درسی که امام خمینی (ره) از سید الشهداء (ع) آموخت
تحلیلی از عاشورا و نقش آن در حرکت های خودجوش مردمی
عباس علیه السلام الگویی برای نسل امروز
اسوه ایثار; الگوگیری از شخصیت حضرت عباس(ع)
حضرت عباس (ع) نمودی از سبک زندگی انسان کامل قرآنی
ماه هاشمیان; ویژگی های فردی حضرت عباس (ع)
بررسی ابعاد شخصیت حضرت عباس علیه السلام در شعر معاصر عربی
ارتباط امام مهدی(ع) با امام حسین(ع)
ماه در نقاب: کرامت حضرت عباس (ع)
تاریخچه پیدایش هیات های عزاداری
علت این که امام حسین علیه السلام در عاشورا جانش را به خطر انداخت
بهترین الگوی سلامت و بهداشت روانی خانواده
چرا شهدا به جایگاه حضرت عباس(ع) غبطه می خورند؟
روز تاسوعا و حوادث جانگداز کربلا
هدایت و تبلیغ در سیره حسینی(ع)
محمد دانشور و کتابهای یک عاشق در وصف زادگاه خویش
جنگ چالدران و تغییر مناسبات سیاسی
هوشنگ سیحون؛ پدر معماری مدرن ایران
جامعه پزشکی؛ مدافعان حوزه سلامت کشور
حسین علیزاده و کسب بیشترین جایزه موسیقی فیلم در جشنواره فیلم فجر

شهید اندرزگو مجاهدی وارسته و ولایتمدار
شهادت رجایی؛ سندی از حقانیت نظام اسلامی در رویارویی با تروریسم
روز پزشک؛ مشارکت بر مبنای صلاحیت
روزنامه طوفان، ندای آزادیخواهی و حقطلبی در عصر مشروطه
کتابخانه ملی؛ گنجینهای ارزشمند از آثار علمی و ادبی
سه رمان از بانوان نویسنده کرمانشاهی
ناکارآمدی رژیم پهلوی؛ زمینهساز ورود متفقین به ایران
کارمندان؛ بازوی پرتوان دولتمردان در توسعه کشور
فریبرز لاچینی؛ نوازنده چیردهدست ایرانی با آوازه جهانی
عباس میرزا و ورود مدرنیته به ایران
فراز و فرودهای مختلف در حیات سیاسی حسن مستوفی
موسی معروفی؛ هنرمندی که ردیف موسیقی ایرانی را زنده کرد
مروری بر کارنامه سیاسی و فرهنگی ابراهیم یزدی
کتاب شعرهای نقرهای منتخبی از اشعار شاعران جوان استان مرکزی
کتاب "انقراض ششم؛ تاریخ غیرطبیعی"
کتاب از هرات تا اوین اثری از فلور یزدانی
کتاب "جغرافیای خوانسار" معرف جامع این خطه کوهستانی اصفهان
کتاب « دوست من ریاضی» نخستین کتاب حوزه کودک در خمین